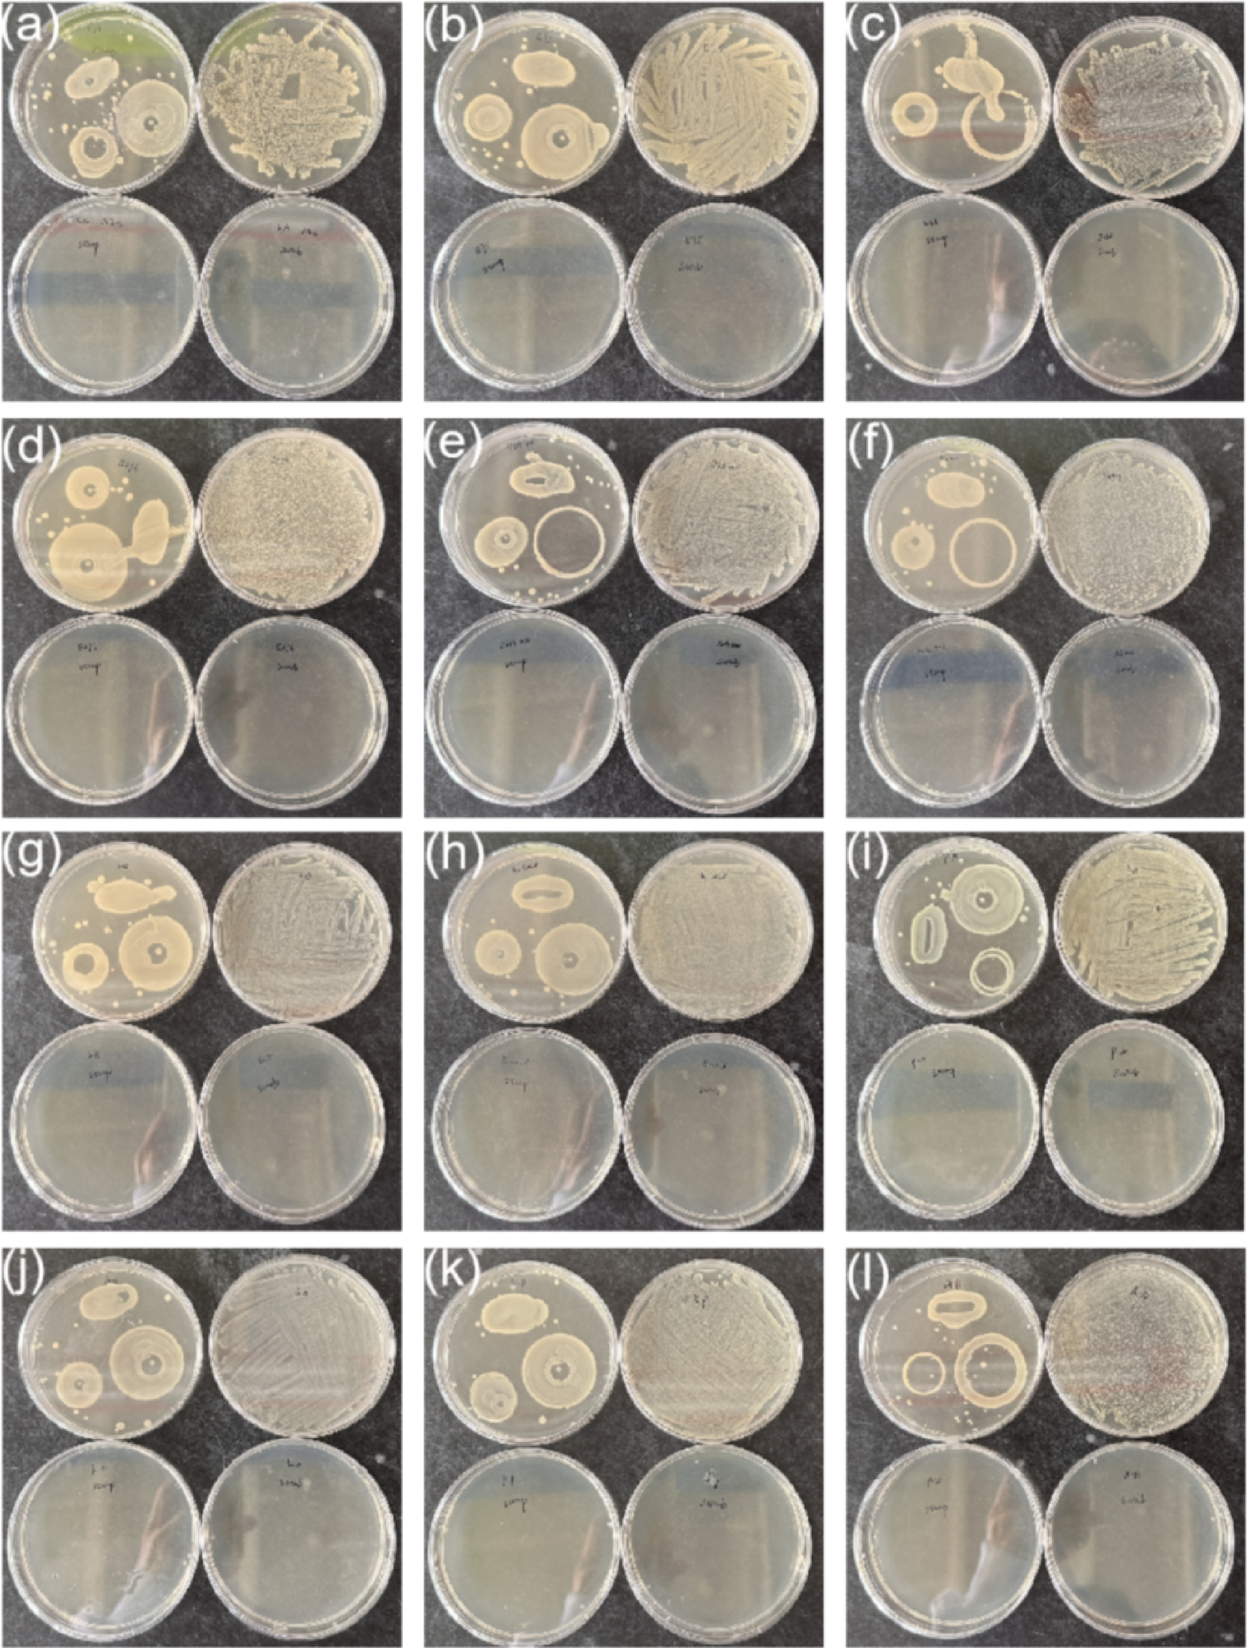
Fig. 3

Fig. 3
Disinfection of nebulizer parts with steam. The different parts of a PARI LC SPRINT Nebulizer handset were contaminated with: (a) S. aureus ATCC15981; (b) S. aureus E75; (c) S. aureus E166; (d) S. aureus E276; (e) S. aureus USA300; (f) S. aureus HG001; (g) S. epidermidis ATCC35984; (h) E. coli ATCC25922; (i) P. aeruginosa ATCC27853; (j) K. oxytoca; (k) K. pneumoniae ATCC15883; (l) A. baumanni ATCC19606. Prior and after 60 s steam exposure, the contaminated mouth piece was replica-plated on LB agar. Bacteria contaminating the connection tube and nozzle were collected by swabbing and subsequently plated on LB agar. Of note, the different bacterial loads on the contaminated nebulizer parts were not quantified. Upper left plate of each panel, replica-plated contaminated mouthpiece; lower left plate, replica-plated contaminated mouthpiece after disinfection with steam; upper right part plate, bacteria contaminating the connection tube and nozzle; lower right plate, bacteria contaminating the connection tube and nozzle after steam disinfection. Three independent replicate experiments were performed (n = 3).
